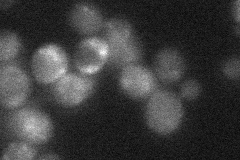
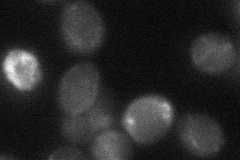

View description
Plasma membrane protein that binds to Bsd2p and regulates ubiquitylation and vacuolar degradation of the metal transporter Smf1p; function is redundant with that of Tre2p; has similarity to transferrin receptors
Localization:
Intensity:
Fold change:
Significance:
-
C’ GFP library in SD

below threshold17.76 -
N' NOP1pr-GFP in SD

punctate,vacuole48.4426 -
N' TEF2pr-mCherry in SD

vacuole65.9709 -
N' NATIVEpr-GFP in SD
below threshold22.3058 -
N' TEF2pr-VC and Cyto-VN in SD
below threshold25.5168 -
C’ GFP library in SD+DTT

cytosol19.981.12No -
C’ GFP library in SD+H2O2

cytosol16.220.91No -
C’ GFP library in Starvation Media

cytosol28.111.58No -
C’ GFP library on the background of Pup2-DaMP

below threshold -
C’ GFP library on the background of CCT mutant

below threshold16.92340.952376No
